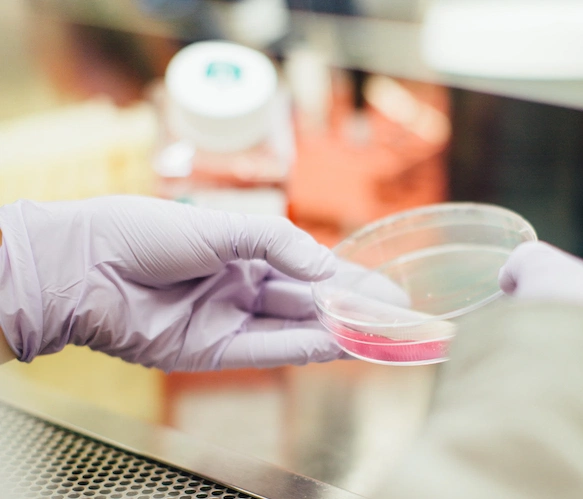
First trials of UK Covid-19 vaccine find it safe with an ‘immune reaction’ First trials of UK Covid-19 vaccine find it safe with an ‘immune reaction’

First trials of UK Covid-19 vaccine find it safe with an ‘immune reaction’
By Jennifer McShane
20th Jul 2020
20th Jul 2020
Researchers at Oxford University described the results as encouraging with much work still to be done
The race for a Covid-19 vaccine gained some momentum today as the first human trials of a Covid-19 vaccine being developed by researchers at the University of Oxford suggest it is safe and triggers two types of an immune response.
According to preliminary research, a Phase 1/2 trial involving 1,077 healthy adults found the vaccine brought about strong antibody and T cell immune responses for up to 56 days and did not produce any strong side effects.
“These responses may be even greater after a 2nd dose, according to a sub-group study of 10 participants,” their notes said.
Despite the early stages of the trial, the results are being described as “encouraging” as the response it provoked in the body show this vaccine could find and attack the virus in the cells.
The trial included 1,077 healthy adults aged 18-55 years with no history of Covid-19, and took place in five UK hospitals between April 23 and May 21.
More research needed
Lead author of the study published in The Lancet today, Professor Andrew Pollard explained: “The immune system has two ways of finding and attacking pathogens – antibody and T cell responses. This vaccine is intended to induce both, so it can attack the virus when it’s circulating in the body, as well as attacking infected cells.
“We hope this means the immune system will remember the virus, so that our vaccine will protect people for an extended period. However, we need more research before we can confirm the vaccine effectively protects against SARS-CoV-2 infection, and for how long any protection lasts.”
“There is still much work to be done before we can confirm if our vaccine will help manage the Covid-19 pandemic, but these early results hold promise,” study co-author Professor Sarah Gilbert said. “As well as continuing to test our vaccine in phase 3 trials, we need to learn more about the virus – for example, we still do not know how strong an immune response we need to provoke to effectively protect against SARS-CoV-2 infection.”
The next stage will be more in-depth Phase Three trails, involving a greater number of participants.
Main photograph: Unsplash
Read more: ‘Zero-Covid island’: Scientists say eradication of Covid-19 is the best way forward
Read more: Parents of babies born during the pandemic to get an additional three weeks of parental leave
Read more: Survey finds 62% of Irish employers are planning a staggered return to work